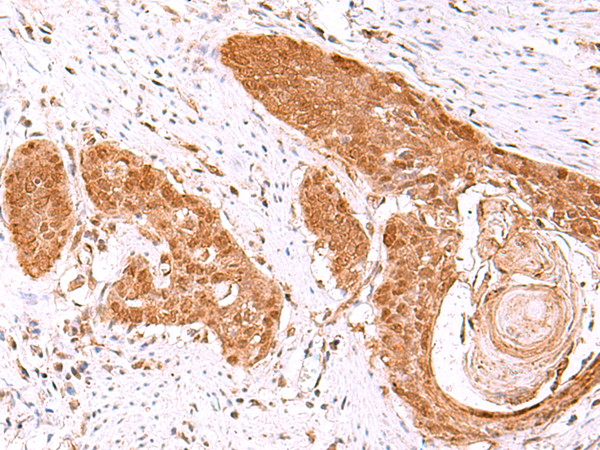

-
分类: 科研抗体货号: P10170别名: NML; KIAA0409应用: WB,IHC反应种属: Human, Mouse, Rat
-
分类: 科研抗体货号: P10150别名: RIC8应用: WB,IHC反应种属: Human, Mouse, Rat
-
分类: 科研抗体货号: P10169别名: HMDRA1; FLB7527; PRO1999应用: WB,IHC反应种属: Human, Mouse, Rat
-
分类: 科研抗体货号: P10149别名: FPS; FPPS; POROK9应用: IHC反应种属: Human, Mouse, Rat
-
分类: 科研抗体货号: P10166别名: dJ283E3.1应用: IHC反应种属: Human, Mouse
-
分类: 科研抗体货号: P10147别名: OHS; RH2; OHST; Rh50; CD241; RH50A; Rh50GP; SLC42A1应用: WB,IHC反应种属: Human, Mouse
-
分类: 科研抗体货号: P10165别名: XE7; 721P; XE7Y; CCDC133; CXYorf3; PRKA17A; SFRS17A; AKAP-17A; DXYS155E应用: WB反应种属: Human
-
分类: 科研抗体货号: P10145别名: KPC2; GBDR1; UBADC1应用: IHC反应种属: Human, Mouse, Rat
-
分类: 科研抗体货号: P10162别名: bA67K19.1应用: IHC反应种属: Human, Mouse
-
分类: 科研抗体货号: P10144别名: RSE1; SAP130; SF3b130; STAF130应用: IHC反应种属: Human, Mouse

鄂公网安备42018502007531号
鄂公网安备42018502007531号

